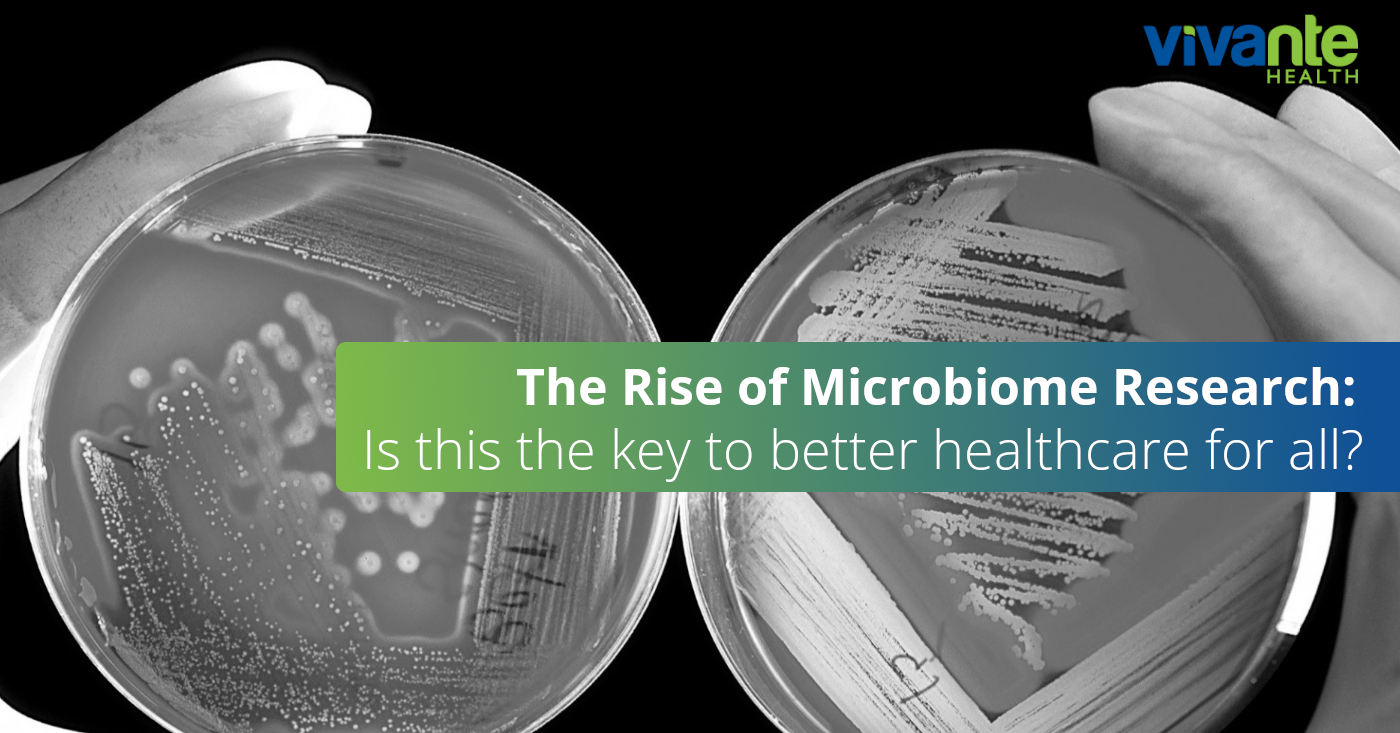
Microbiome research

Taking Risks to Cure IBS
At Vivante, we’re the digestive health experts. We live for this stuff. Here’s a short summary of another academic article our gut health nerds found interesting… What would you do to cure your IBS? That’s what participants of one international study were asked. Approximately 2,000 irritable bowel syndrome (IBS) sufferers described the severity of their…
Details